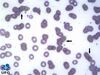

São considerados leucócitos polimorfonucleares:
Neutrófilos, Basófilos e Eosinófilos
São considerados leucócitos agranulocitos/ mononucleoares:
Linfócitos e Monócito
Basófilos se relacionam com reações alérgicas (Liberam histamina)
V ou f
Verdadeiro
Linfócitos são células responsáveis por responde imune _____________
específica
Linfócitos B
principal função
Produzir anticorpos
Linfócitos T
principal função
cite 2
- diretamente: destruindo células infectadas por vírus
- indiretamente: mediando as ações de outros leucócitos;
Monócitos viram __________ atuando na ___________
macrófagos
fagocitose
Hematopoiese
Célula indiferenciada pluripotente pode seguir duas linhagens diferentes
a) Linhagem linfoide:
b) Linhagem mielóide:
a) Linhagem linfoide: vira linfócito (B, T, ou NK)
b) Linhagem mielóide: Vira todos os outros tipos células da série branca e série vermelha, incluindo plaquetas;
medula óssea
até os 2 anos de idade é encontrada em __________
qualquer osso
medula óssea
no adulto, é encontrado em:
osso ilíaco, vértebras, esterno, costelas e ossos longos dos membros
Conforme os percursores eritróides amadurecem:
- tamanho das células vai diminuindo
Diminui a razão núcleo/citoplasma - Núcleo diminui, cromatina se condensa; núcleo vai ficando arroxeado/ azul até ser ejetado da célula; (Ejeta antes de virar reticulócito)
Verdadeiro ou falso
Verdadeiro
Desenvolvimento do eritrócito
Proeritroblasto -> Eritroblasto basófilo -> Eritroblasto policromatófilo -> Eritroblasto ortocromatico -> Reticulócito -> Eritrócito;
Diferencie o reticulótico do eritrócito
Reticulócito:
Não possui núcleo
Ainda é capaz de produzir hemoglobina (Pois possui resquícios de RNA)
Fica de 24- 48 horas no sangue -> Baço (Sofre ação de macrófagos) -> Eritrócitos maduros;
Eritrócito (Hemácia):
Não possui núcleo
Não possui resquícios de RNA, não produz mais hemoglobina)
Quais os tipos de hemoglobina existentes e qual sua proporção num indivíduo saudável?
Tipos de hemoglobina:
-Hemoglobina A1 ( 95%)
-Hemoglobina A2 (1-4%)
-Hemoglobina fetal ( HbF) (1%)
-Variantes patológicas: hemoglobina S, hemoglobina C, hemoglobina E, entre outras;
Granulopoese:
Mieloblasto -> Promielócito -> Mielócito -> Metamielócito -> Bastonete (Bastão) -> Neutrófilos Segmentados
Linfopoese:
Linfócitos B saem maduros da medula óssea -> Se diferenciam em plasmócitos (qnd encontram um antígeno em um órgão linfoide secundário e secretam anticorpos no tecido)
Linfócitos T - Não saem maduros da medula óssea, precisam migrar para o timo para amadurecer.
órgãos linfóides secundários
- tonsilas,
- agregados de linfócitos e céls. Apresentadoras de antígenos nos pulmões
- mucosa do trato digestivo, incluindo placas de peyer;
Defina manchas de gumprecht
são restos celulares provenientes de linfócitos que se rompem durante a produção do esfregaço
Onde ocorre a maturação das plaquetas?
medula óssea
Cite exemplos:
- Microcitose:
- Macrocitose:
- Megalocitose:
- Microcitose: Anemia ferropriva, anemia hemolítica, anemia sideroblástica e talassemias;
- Macrocitose: Deficiencia de vitamina b12 e de ácido fólico, anemia aplástica e cirrose hepática;
- Megalocitose: (Maiores do que na macrocitose): Anemia megaloblástica;
Defina Hipercromia no contexto de hemácia e dê 2 exemplos
quantidade de hemoglobina maior nas hemácias - diminuição do halo central (Anemia megaloblástica e esferocitose)
Defina Hipocromia no contexto de hemácia e dê 3 exemplos
Hipocromia : quantidade de hemoglobina menor nas hemácias - aumento do tamanho do halo central; (Anemia ferropriva, sideroblástica, talassemias, etc)
Policromasia/ Policromatofilia:
O que sugere?
hemácias c/ coloração mais basofílica ( + roxa ou mais cinza)
-> sugere reticulócitos na amostra; (RNA são moléculas basofílicas e os reticulócitos tem resquícios de RNA); - Anemias hemolíticas;
Significado de Poiquilocitose/ Pecilocitose:
Alteração na forma dos eritrócitos;